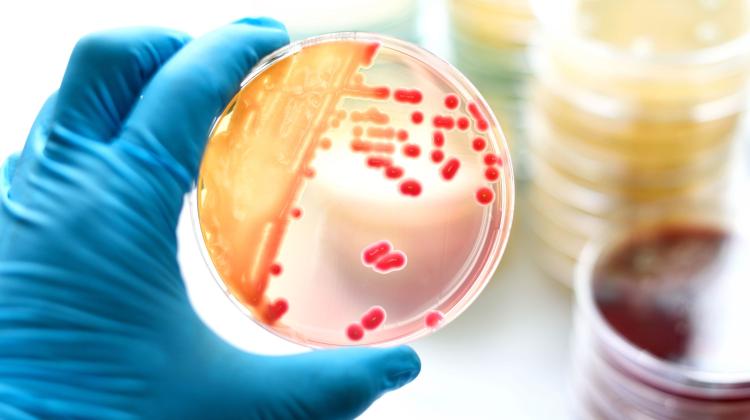

В среду комитет Сената по здравоохранению рассмотрел стандарты лечения сепсиса. Как подчеркнули участвовавшие в дискуссии эксперты, необходимость создания национального регистра сепсиса и общенациональных стандартов диагностики и лечения обсуждается уже около 20 лет. Все еще нет эффекта.
Сепсис – это быстрая генерализованная воспалительная реакция организма на инфекцию (также известная как генерализованная инфекция). Его вызывают циркулирующие в крови микроорганизмы, чаще всего бактерии и их токсины, а также грибы и реже вирусы. В наиболее тяжелых случаях развивается септический шок, который является опасным для жизни состоянием, поскольку приводит к органной недостаточности. Смертность при сепсисе очень высока.
Проф. Анджей Кюблер, президент Ассоциации «Преодолеем сепсис» и многолетний руководитель кафедры и клиники анестезиологии и интенсивной терапии Вроцлавского медицинского университета, отметил, что как в Польше, так и в мире трудно предоставить точную статистику. об инфекциях и смертности от сепсиса. По его словам, точкой отсчета является доклад, опубликованный в "The Lancet" в 2020 году, согласно которому число случаев сепсиса в мире достигает 50 миллионов случаев в год и умирает 11 миллионов человек. Польские данные, приведенные проф. Кюблер говорит, что около 100 000. случаев заражения и 26 тыс. смертей в год. "Эти очень серьезные цифры показывают, насколько велика угроза, о которой мы говорим", - сказал он.
По словам проф. Кюблер, препятствием для сокращения этих статистических данных является отсутствие общей осведомленности – в обществе и среди медицинских работников – о том, что такое сепсис. Чтобы изменить это, необходимы социальные кампании и обучение медицинского персонала. Также необходимо следить за состоянием пациентов, перенесших сепсис, и обеспечивать им программу ухода. Такие решения существуют, например, в Великобритании.
Но главное, подчеркнул эксперт, - это создание общенационального регистра случаев сепсиса, который позволит нам определять, каких пациентов лечат, где, как и с какими результатами.
Проф. также рассказал о необходимости создания реестра. Мирослав Чучвар, заведующий 2-м отделением анестезиологии и интенсивной терапии Независимой государственной клинической больницы в Люблине. Он подчеркнул, что пандемия COVID-19 показала, чего не хватает в системе для более эффективной борьбы с сепсисом. "Регистр сепсиса окажет положительное влияние на качество лечения в больницах. Отсутствие системных решений не идет на пользу ни пациентам, ни персоналу, ни плательщикам", - подчеркнул он.
Специалист коснулся деятельности Большого оркестра рождественской благотворительности, который посвятил прошлогодний финал борьбе с сепсисом. Для этой цели компания собрала 243 миллиона злотых, на которые, в частности, приобрела: оборудование для быстрой диагностики инфекций. "Ежи Овсяк тогда сказал, что мы должны победить сепсис и вместе мы сможем победить это зло. Мы хотим добиться этой победы, но пока нам это не удалось", - сказал врач.
По его словам, ситуацию улучшит, в частности: создание общенациональной системы скоординированной помощи, благодаря которой врачи в каждой больнице будут знать, среди прочего, где находится референтный центр (специализирующийся на лечении сепсиса), каковы критерии госпитализации и кто отвечает за транспорт.
Заместитель министра здравоохранения Уршула Демков отметила, что определение того, что такое сепсис, также является проблемой. «Важно научить врачей распознавать эту патологию», — сказала она. Она сказала, что министерство работает над оценкой некоторых элементов диагностики сепсиса, чтобы ускорить диагностику.
По словам председателя сенатского комитета по здравоохранению Беаты Малецкой-Либеры (Гражданская коалиция), все элементы, упомянутые участниками дебатов, требуют реализации. "Ранняя диагностика, использование современного оборудования, создание регистра и стандартов, организация обучения - все это необходимо, если мы хотим системно бороться с сепсисом", - отметила она.
Малецка-Либера также считает, что необходимо создать команду по сепсису, в которую войдут представители Министерства здравоохранения, врачи и диагносты. (ПАП)
Автор: Анита Карвовска
акар/рал/мхр/